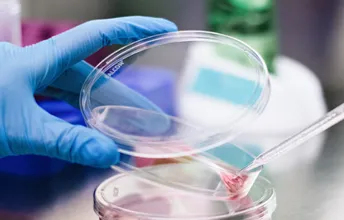

For a world without incurable cancers
Institut Curie, the leading French cancer treatment and research center
Cancer types
Find out more about the cancer types we treat at Institut Curie.

Excellence, from research to care
Let's work together

Together, for women
The Institut Curie, Université PSL 
and INSERM create the Institute of Women’s Cancers
A unique structure of international scope that places women at the heart of research and innovation
Our news

Institut Curie
A legacy of innovation
Marie Curie's values continue to drive the institute: furthering the scientific progress, for the benefit of all.

United in the face of disease
International cooperation
Institut Curie's high level of expertise is reflected in its scientific collaborations, publications in prestigious journals, participation in international congresses, care of foreign patients and training of doctoral students and healthcare professionals from different countries.